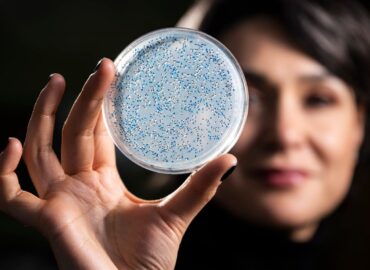
10887 Mokslininkai Atkūrė 32 Milijardų Metų Senumo Fermentą Siek

Senovinio fermento atkūrimas
Viskonsino-Madisono universiteto tyrėjai „prikėlė“ fermentą, kuris egzistavo prieš maždaug 3,2 milijardus metų, kad geriau suprastų gyvybės kilmę Žemėje. Naudodami sintetinės biologijos metodus, mokslininkai atkūrė senovines pagrindinių fermentų versijas, tarp jų ir nitrigenazę – baltymą, kuris paverčia atmosferos azotą į junginius, prieinamus gyviems organizmams.
Nitrigenazės izotopiniai „parašai“
Profesorė Betul Kaçar ir doktorantė Holly R. Racker tyrė, kaip šie fermentų „protėviai“ veikė ankstyvosios Žemės sąlygomis. Paaiškėjo, kad izotopiniai „parašai“, kuriuos palieka nitrigenazė, išlieka nepakitę milijardus metų, todėl jie gali būti laikomi patikimais biologinės veiklos žymenimis geologinėje istorijoje.
Izotopinių parašų reikšmė
Izotopiniai parašai – tai charakteringi elementų izotopų santykiai (šiuo atveju azoto), kurie atsiranda biocheminių reakcijų metu. Jei toks „parašas“ yra stabilus laike, jis gali būti naudojamas senovinio gyvenimo pėdsakams uolienose ir mėginiuose iš kitų pasaulių aptikti.
Projekto reikšmė
Projektas įgyvendintas MUSE konsorciumo (Metal Utilization and Selection across Eons) rėmuose, kurį remia NASA misijos, siūlančios naujas evoliucines įžvalgas mikrobiologijoje. Gauti rezultatai stiprina galimybes ieškoti gyvybės kitose planetose, ypač naudojant azoto izotopus kaip patikimą biologinių procesų indikatorių.